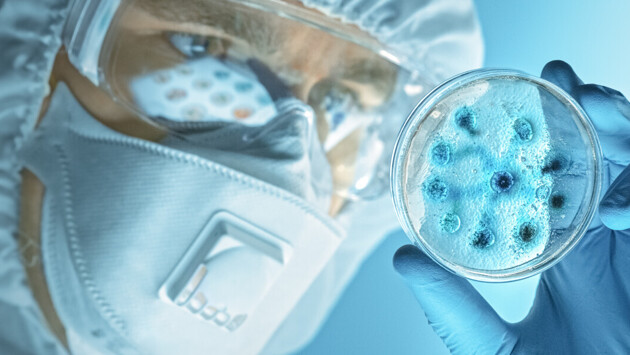

Какие вирусы могут вызвать развитие рака
Какие вирусы могут вызвать онкологию, как узнать, что вы в зоне риска, и что делать в этом случае? Об этом врачи-онкологи рассказали в интервью MIR24.TV.
«Существуют вирусы, которые способствуют развитию злокачественных опухолей, – говорит врач-онколог Института онкологии Европейского медицинского центра (ЕМС), к.м.н. Юлия Вахабова. – В первую очередь – это вирус папилломы человека (ВПЧ). Типов этого вируса существует очень много, больше нескольких сотен, и лишь некоторые способны вызывать рак. Опасность представляют в основном 6, 11, 16 и 18 типы. ВПЧ чаще всего становится причиной развития рака шейки матки у женщин. Но также может способствовать возникновению рака языка, ротовой полости, гортани, половых органов у представителей обоих полов. В зоне риска находятся все, кто ведет половую жизнь, так как ВПЧ передается преимущественно половым путем. Сейчас от ВПЧ существует вакцина, и она очень эффективна. Если у вас еще не обнаружен данный вирус, можно от него вакцинироваться в любом возрасте. Но целесообразнее всего прививать девочек и мальчиков до начала половой жизни, то есть примерно с 12 лет».
По словам врача, если у вас все же обнаружен ВПЧ, то не стоит впадать в панику. Во-первых, не все его типы вызывают рак, во-вторых, нет гарантии, что именно у вас разовьется злокачественная опухоль. Просто надо будет более тщательно следить за своим здоровьем. Женщинам надо проходить регулярные осмотры у гинеколога – примерно раз в полгода. Чтобы была возможность обнаружить рак в самом начале развития, когда он хорошо поддается лечению. Лучше всего проконсультироваться со своим врачом, обсудить проблему и составить график плановых осмотров. Также людям с ВПЧ надо проходить регулярные скрининги по всем органам, которые находятся в зоне риска. Кроме того, очень желательно отказаться от курения. Табачный дым сам по себе является канцерогеном, который повышает риск развития любого онкологического заболевания, и не только рака легких.
Кроме ВПЧ, причиной развития раковой опухоли могут быть вирусные гепатиты В и С. Они являются одним из наиболее значимых факторов риска развития гепатоцеллюлярного рака (ГЦР). Сейчас вирусные гепатиты успешно лечатся, но основная опасность заключается в том, что они точно так же, как и рак, на начальных этапах протекают бессимптомно и человек может даже не догадываться, что болен, пока болезнь не перейдет в хроническую стадию. Единственный способ узнать об этом – периодически сдавать анализы крови на наличие этого вируса, если вы находитесь в зоне риска. В зону риска попадают: медицинские работники, люди на гемодиализе, те, кто пользуется чужими предметами личной гигиены (маникюрные принадлежности, бритвы, зубные щетки и т.д.), ведет беспорядочную половую жизнь, употребляет наркотики внутривенно и т.д.
Пациенты, страдающие вирусными гепатитами, должны регулярно проходить обследования для раннего выявления ГЦР. Примечательно, что даже пациенты, у которых на фоне противовирусной терапии получен устойчивый вирусологический ответ, остаются в группе повышенного риска. Поэтому им надо наблюдаться у гепатолога-инфекциониста.
«От вирусного гепатита В тоже существует вакцина, и она тоже очень эффективна, – говорит Юлия Вахабова. – Сейчас новорожденных вакцинируют от гепатита В прямо в родильных домах. Этой защиты хватает примерно на 20 лет. Но после этого вакцинацию надо повторять. Сделать это можно в любом медицинском учреждении в любом возрасте. Вакцина практически не имеет противопоказаний. В свое время именно вакцинация от гепатита В спасла Китай, где отмечался высокий процент развития рака печени».
Горячо рекомендует вакцинацию как способ профилактики злокачественных новообразований и старший научный сотрудник Онкологического центр им. Блохина Игорь Самойленко. «Если мы сможем широко ввести вакцинацию против вируса папилломы человека, то мы ждем, что заболеваемость этими злокачественными образованиями может быть существенно снижена, – говорит врач-онколог. – И если вы еще не проконтактировали с вирусом папилломы человека, то сегодня всем доступна вакцинация. Так, в Москве эта прививка даже введена в бесплатную программу вакцинации ля школьников».
«Если вирус уже присоединился, то это не означает, что у вас непременно разовьется рак. Это не так. В большинстве случаев эта инфекция проходит самостоятельно и не требует какого-то вмешательства. Но после перенесенного заболевания требуется более внимательное наблюдение у врача. Женщинам, которые находятся в зоне наибольшего риска, достаточно использовать все то, что делается при обычном гинекологическом осмотре. И если доктор увидит, что есть какие-то отклонения на шейке матки, то могут быть назначены дополнительные диагностические манипуляции, чтобы убедиться, что на этом участке не развилось предопухолевое состояние», – объясняет специалист.
Другие случаи, когда вирусные заболевания являются провокатором развития рака, куда более редки. По словам Игоря Самойленко, существуют Т-лимфотропные вирусы человека (HTLV) первого и второго типа, которые могут в 4-5% случаев порождать лимфомы или вирусную лейкемию.
Также спровоцировать развитие некоторых раковых опухолей может человеческий герпес четвертого типа – вирус Эпштейна–Барра (ЭБВ). Роль этих вирусов в образовании отдельных вариантов рака желудка и некоторых видов лимфом тоже известна и установлена. Но онкологические заболевания развиваются только у небольшого количества людей, зараженных ЭБВ.